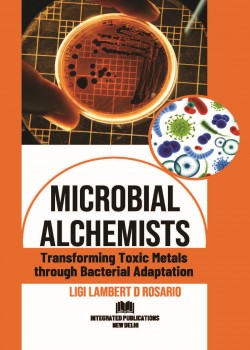
Microbial Alchemists

Categories
-
Trade and Commercial Magazines
- Accounting and Taxation
- Agriculture Sector
- Apparel Trade Industry
- Aquaculture And Fisheries
- Architecture and Interior Design Magazines
- Auto and Automobile Industry
- Aviation Industry
- Bakery and Confectionery Industry
- Business and Commerce
- Cable and Satellite Industry
- Cargo and Logistics Industry
- Cement Industry
- Chemical Industry Magazines
- Cinema and Film Industry
- Civil Construction Industry
- Civil Defense and Military Sector
- Coal Industry
- Computer Science
- Education and Training Industry
- Electrical and Power Industry
- Electronics and Gadget
- Equipment
- Fashion, Beauty And Lifestyle
- Finance Sector
- Food and Beverages Industry
- Foundry Industry
- Franchising and Brand Retailing
- Gems and Jewellery Industry
- Glass Industry
- Hardware and Sanitary
- Healthcare And Medical Industry
- Hotel and Hospitality Industry
- Human Resource Management
- Industrial Manufacturing
- Information Technology
- Infrastructure sector
- Leather and Its Allied Industries
- Liquor Industry
- Marketing, Advertising and Media
- Medical Industry
- Minerals and Metals Industry
- Paint and Coating Industry
- Paper Industry
- Pharma and Pharmaceutical Industry
- Plastics And Polymers Industry
- Poultry Farm Industry
- Power and Energy
- Printing and Packaging Technology
- Pumps Industry
- Retail Trade Industry Magazine
- Rubber Industry
- Science and Technology
- Shipping and Maritime
- Technology Industries
- Telecom Industry
- Textile and Garment Processing
- Tools and Machinery Technology
- Tour and Travel Industry
- Trade Magazines on Various Industries
- Transport Industries
- Water Treatment Industry Magazine
- Wood And Timber Industry Magazine
Buy Your Required Trade and Commercial Magazines From Following Industries
-
Special & General Interest Magazines
- Academic
- Animation
- Art, Culture and Literature
- Astrology Magazine
- Career and Competition Magazines
- Children
- Gaming
- General Interest
- Health And Fitness
- History
- Interior And Exterior Design
- Law and Order
- Life Style and Fashion
- Magazines on Various Topics
- Men Interest
- Parenting
- Pets And Animals
- Photography
- Socio Political
- Sound And Music
- Sports And Games Magazines
- Travel
- Wildlife Magazines
- Women Interest
Buy Your Required Special And General Interest Magazines From Following Topics
-
Journals on Various Topics
- Aging
- Agriculture Journals
- Alcohol and Drugs
- Animal Husbandry and Veterinary Sciences
- Animation Sector
- Anthropology
- Architect Design and Interior Journals
- Arts, Culture, Humanities and Literature
- Biology, Zoology and Entomology
- Biotechnology and Biochemistry
- Business, Commerce and Management
- Chemistry And Chemical Engineering
- Child
- City and Community
- Clinical Medicine - Neurology
- Clinical Medicine - Vascular and Surgery
- Communication and Media Studies
- Computer Science Journal
- Criminology
- Economics
- Education Journal
- Electrical And Electronics
- Engineering And Information Technology
- Events Journals
- Family Studies
- Feminist Studies
- Food and Nutrition
- Forestry
- Garments
- Gender Studies
- Geology, Environment and Earth Science
- Healthcare Journals
- Historical Journals
- Immunology
- Information Technology (IT)
- Journalism
- Journals on Multiple Topics
- Language
- Law
- Leadership
- Life Science and Biotechnology
- Management
- Marketing
- Mathematics
- Mechanical
- Medicals
- Mobile Applications and Technologies
- Multidisciplinary
- Networking
- News
- Nursing
- Pharmacy, Botany And Ayurveda Medicine
- Philosophy
- Physics and Chemistry
- Politics and International Relation
- Psychology
- Regional Studies
- Rehabilitation
- Research Methods
- Science and Technology.
- Social Activities
- Sociology
- Sports and Physical Education
- Theology
- Tourism and Travel
- Urban Studies
- Wood Industry
Choose And Buy Your Required Journals From Below Topics
-
Books
- Agriculture
- Ayurveda
- Biology
- Biotechnology, Biochemistry and Bioscience
- Chemical Industry
- Commerce and Management
- Dentistry
- Education
- Engineering and Technology
- Environmental Science
- Fibres in Textile Industries
- Fisheries
- Food Science
- Healthcare Industry
- Labour Industries
- Medicine
- Miscellaneous
- Paints and Coatings Technology
- Product Industry
- Veterinary and Animal Husbandry
Choose And Buy Your Required Books From Following Topics & Industries
- International Magazines
-
PI, Quotation & Payment Option
Home
All Category
All Sub Categories
Loading...
Showing 3249 to 3264 of 3323
Magazine(s) / Journal(s) Found: